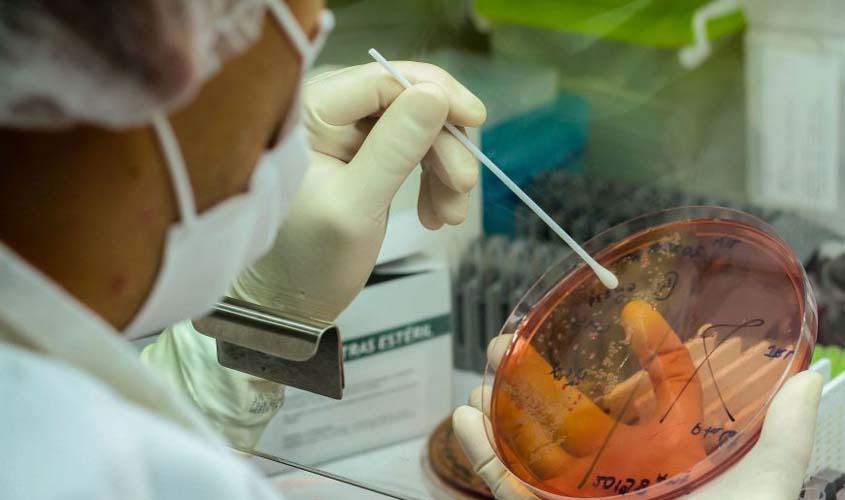
Rondônia ultrapassa os 200 mil testes para Covid-19 e permanece entre os primeiros no ranking da transparência

MP recomenda revogação de decreto que autoriza funcionamento de atividades como cinema e esporte coletivo amador
No documento, o MP também ressalta caber à municipalidade atuar de forma que se diminua o número de aglomeração e de exposição de pessoas, evitando-se pôr a população em risco
O Ministério Público de Rondônia emitiu recomendação ao Prefeito de Vilhena, em que o orienta a revogar, em caráter de urgência, no prazo de 24 horas, o Decreto Nº 50.229/2020, a fim de se adequar às medidas implementadas pelo Governo do Estado, empregando critérios estabelecidos na Fase 2, relativa ao Plano Estadual de Enfrentamento à Covid-19.
O Decreto Nº 50.229/2020, que inclui e altera dispositivos de atos anteriores e dispõe sobre medidas para enfrentamento à pandemia, flexibiliza o funcionamento de atividades não essenciais na cidade, a exemplo da prática de modalidades esportivas amadoras coletivas e da abertura de cinemas, ambas proibidas na Fase 2 do Plano Estadual.
De acordo com informações do Boletim Estadual do Coronavírus, edição nº 190, até as 19h, do dia 21 de setembro de 2020, o Município de Vilhena registrou 27 novos casos confirmados para Covid, havendo, atualmente, 344 casos ativos na cidade. Os óbitos pela doença já atingem o número de 57, para moradores locais, e de nove, para pacientes vindos de outros municípios.
Ao emitir a Recomendação, o Promotor de Justiça Paulo Fernando Lermen destaca que a flexibilização do funcionamento de atividades não essenciais na cidade ocorre em afronta aos decretos do Governo do Estado e sem a realização de estudos detalhados sobre o risco de contágio para a população.
No documento, o MP também ressalta caber à municipalidade atuar de forma que se diminua o número de aglomeração e de exposição de pessoas, evitando-se pôr a população em risco.
Informe Sinjur sobre assembleia que elegerá membros da comissão eleitoral
Esclarece, por fim, que foram inscritos e deferidos as inscrições de sete candidatos e, destes, serão os três que mais receberem votos para comporem a comissão supracitada, conforme normas de editais e estatutárias
Rondônia ultrapassa os 200 mil testes para Covid-19 e permanece entre os primeiros no ranking da transparência
“A decisão de adotar sempre as melhores medidas para enfrentar a Covid-19 foi fundamental em nosso trabalho”, disse Fernando Máximo, destacando a importância de se antecipar providências (medicar) antes de sua manifestação plena, resultado das ações de testagem por meio do drive-thru,
Covid-19: Rondônia com 64.923 casos e 1.333 mortes; Porto Velho tem 29.744 infectados
Hoje (26) foram registrados cinco óbitos por Covid-19 em Rondônia, três homens em Porto sendo (59, 73 e 87 anos), um homem de 28 anos de Cacoal e uma mulher de 84 anos do município de Ji-Paraná

Comentários
Seja o primeiro a comentar
Envie Comentários utilizando sua conta do Facebook